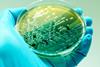
shutterstock_524153776

All Sterility and rapid methods articles – Page 4
-
 News
NewsRapid method for whole-genome fungal ID
The novel technique for whole-genome analysis of fungal species is “highly suitable” for quality and safety monitoring of medicinal materials, the paper suggests.
-
 Article
ArticleApplication of NGS to enhance the molecular monitoring of CML patients
Q&A with Dr Jin Li and Dr Chad Galderisi of ICON Specialty Laboratory Solutions on how Next Generation Sequencing can support more accurate monitoring of chronic myeloid leukemia patients.
-
 Article
ArticleGuide to Testing 2024
In this Guide to Testing articles explore limit of detection requirements for microbial testing of short-shelf-life products and sustainable endotoxin testing.
-
 Article
ArticleEuropean Pharmaceutical Review Issue 2 2024
European Pharmaceutical Review Issue 2 includes articles on cell and gene therapy, from supply chain and manufacturing to microbial testing.
-
Webinar
Testing of rapid microbiological methods (RMMs) - demonstrating equivalence to existing methods in alignment with USP <1223>
Watch this on demand webinar to hear about the latest RMM technology and how it aligns with USP testing criteria. This webinar will cover testing strategy, and data will be presented to effectively demonstrate suitability of the Soleil for its intended use and correlation to plate counts.
-
 News
NewsMicrobe-carrying particle recovery efficacy with manual surface sampling
Three different contact plate methods were tested to determine a convenient manual surface sampling technique for microbial contamination recovery, the paper explained.
-
 News
NewsStudy monitors particles and falling bacteria in biosafety cabinets
The type of clothing worn in aseptic manufacturing areas may impact the number of particle and airborne bacteria detected in biosafety cabinets.
-
 News
NewsMicrobial burden assessment of solid pharmaceutical products
Employing an automated, alternative microbiological method (AMM) means water activity could be used as a microbial indicator for bioburden assessment in tablets and capsules, a study suggests.
-
 Video
VideoWebinar: How Pfizer utilises Enzyme Indicator technology for bio-decontamination validation
Melanie Eggers is a Sterilisation Validation Project Support Engineer at Pfizer Belgium. In this webinar, she explains how Pfizer has adopted Enzyme Indicator (EI) technology for its VHP bio-decontamination procedures. She outlines the differences in EIs compared to more traditional Biological Indicators and the way in which Pfizer utilises the ...
-
 News
NewsAchieving FAIR bacterial identification
A study has reported a noninvasive assay for detecting Gram-negative bacteria biofilms that do not disrupt the pattern of bacterial growth.
-
Webinar
Comprehensive evaluation of Growth Direct® Rapid Sterility for microorganism detection
Discover the extensive panel testing done to evaluate the new, innovative sterility testing platform, Growth Direct® Rapid Sterility.
-
 News
NewsControl strategy could facilitate faster bioburden detection
According to the paper, the control strategy for rapid bioburden testing provides manufacturers with enhanced capabilities for process control.
-
 News
NewsMould study highlights safer far-UVC light cleaning alternative
Research suggests that to prevent common mould growth, low-dose far-UVC light could be applied as a chemical-free addition to manual cleaning of indoor surfaces.
-
 Report
ReportPharma Horizons: Environmental Monitoring
This report is dedicated to exploring some of the latest advances in pharmaceutical environmental monitoring, covering topics from contamination control and cleanroom validation through to emerging technologies for bacterial endotoxin testing.
-
Whitepaper
Solution brief: Environmental monitoring software
Monitoring microbial contamination levels at various stages requires focused, independent software with extended controls over microbial management. Digital monitoring of contaminants and their sources helps understand microbial behavior and trends. Thus, a reinforced, data- driven environmental monitoring mechanism is the key to maintaining controlled lab spaces for microbial trend analysis. ...
-
 News
NewsMycoplasma testing market expected to value nearly $2 million by 2031
Technology innovations and a stronger focus on developing novel drugs to treat chronic diseases, are key drivers for the global mycoplasma testing market up to the next decade, research states.
-
 News
NewsInnovative method could offer cost-effective sterilisation approach
The new sterilisation method could provide an affordable, rapid approach for preparing microbiological culture media, research suggests.
-
News
NewsRapid pseudomonas aeruginosa detection method developed
Research suggests the rapid detection method “will enable the timely implementation of microbiological monitoring strategies for large batches of medications”.
-
 News
NewsPreventing fungal contamination in pharmaceuticals
While fungal contamination detection in pharmaceutical manufacturing remains a challenge, preventive practices and policies must be followed, research states.
-
Webinar
Enhancing biopharma workflows with the power of UV/Vis spectroscopy
Discover the valuable role ultraviolet-visible spectroscopy can play in quickly and accurately monitoring a drug as it moves through the research & development workflow and enabling quality and regulatory compliance through the manufacturing process.



